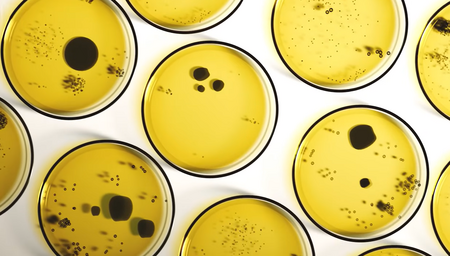
Testiranje blata

Črevesne glivice
Črevesne glivice predstavljajo le majhen del črevesne flore – komaj 0,1% do 1%. Vse ostalo so bakterije.
Starejša študija je pokazala, da ima 65% ljudi kandido. In kandida je le ena od gliv. Toda večina med njimi ne zboli. Zakaj?
Zato, ker glivice enako kot gobe v naravi potrebujejo posebne pogoje za svojo razrast.
Kateri dejavniki ustvarjajo te posebne pogoje in rušijo črevesno floro ter povzročijo bolezen, boste izvedeli v pričujočem prispevku dr. Ulricha Selza.

Dr. med. Ulrich Selz
Zgodnji znaki, da imate črevesne glivice
Glivice živijo v skoraj vsakem črevesju in pri večini ljudi jih je mogoče jasno zaznati. Toda brez panike. Dokler je vaš imunski sistem močan, običajno ostanejo neškodljivi potniki.
Kaj pa se zgodi, ko vaš mikrobiom postane neuravnotežen, recimo po zdravljenju z antibiotiki ali protibolečinskih zdravilih ali zaradi stresa ali slabe prehrane?
Takrat lahko ti mikroorganizmi nenadoma prevzamejo nadzor in začne se proces, ki ga mnogi ljudje opazijo šele, ko se pojavijo simptomi, kot so driska z napihnjenostjo ali kronična utrujenost brez prepoznavnega vzroka.
V nadaljevanju boste izvedeli, kaj se v resnici skriva za črevesnimi glivicami, kakšni so zgodnji opozorilni znaki in kaj lahko storite, če imate črevesne glivice.

Morda ste primer kot ena izmed mojih pacientk, Melanie, stara je 35 let, mati dveh majhnih otrok, zelo zdravstveno ozaveščena, veliko se ukvarja z zdravo prehrano in ukrepi za zdravo življenje. Težava pa je bila v tem, da je bila že tedne povsem spremenjena oseba.
Prišla je k svojemu zdravniku in povedala, da ima nenehno napihnjen trebuh, da je utrujena, razdražljiva in da ima v glavi občutek megle. Opravil je krvne preiskave in izvidi niso pokazali nobene anomalije. Vse je bilo normalno: jetra, ledvice, krvni sladkor in tako naprej. Nato jo je poslal k prvemu gastroenterologu, ki je menil, da gre za sindrom razdražljivega črevesja. Drugi je nato rekel, da gre za psihosomatsko bolezen in takoj predlagal antidepresiv.
Zatem pa je prišla k meni v ordinacijo. Na sumu se imel kandido, zato smo opravili razširjen test blata. Toda rezultati so presenetili celo mene. Sploh ni bila kandida!
O tem, kaj se je pokazalo, bom povedal kasneje. Najprej si pojasnimo vlogo gliv/glivic v črevesju.
Glivice so del normalne črevesne flore
Glivice so del normalne črevesne flore in, kot že omenjeno, jih je mogoče najti pri večini ljudi.
Vendar predstavljajo le zelo majhen del črevesne flore, komaj 0,1 do 1 %, torej res zelo majhen del. Težava s temi črevesnimi glivami se začne šele, ko nekatere med njimi prevzamejo nadzor.
Morda se spomnite 80. in 90. let. Vsakdo, ki je takrat šel k naturopatu ali zdravilcu, je zagotovo odšel domov z navodilom za radikalno dieto proti sladkorju. Diagnoza je bila črevesne glive. V bistvu pogosto niso bili daleč od resnice.
Večina gliv v črevesju ne povzroča bolezni.
Dandanes lahko glive precej dobro laboratorijsko merimo.

Črevesne glive lahko zelo dobro diagnosticiramo. Najdemo veliko kandide, veliko kvasovk, Saccharomyces, Aspergillus, Penicillium in tudi Malassezia furfur. Malassezia furfur je kvasovka, ki v resnici živi na koži, včasih pa jo lahko zaznamo tudi v črevesju.
Starejša študija je pokazala, da ima 65 % ljudi kandido. Nobenega dvoma ni, da bi prekomerna rast te glive zagotovo povzročila bolezen. Dobra novica je, da to vendar ne prizadene večine ljudi. Dokler se nič ne zgodi, je vse v redu.
Raznolikost gliv je bistveno manjša in bolj nestabilna kot svet bakterij. Zato je večja verjetnost, da boste imeli težave z bakterijskim svetom kot pa za glivami. To sem že večkrat pojasnil, ko sem govoril o težavah z glivicami.
Kadar pa obstajajo dejavniki, ki pospešuje razrast črevesnih glivic, se lahko težave zgodijo zelo hitro in hitro eksplodirajo. Med dejavniki mamo nekaj starih znancev.
Največji dejavniki tveganja
Antibiotike sem že omenil. Ti so neverjetno velik problem v konvencionalni medicini na intenzivni negi, zlasti pri ljudeh z oslabljenim imunskim sistemom. Torej tam, kjer namerno zaviramo imunski sistem, da bi s tem zatrli neko drugo bolezen. V teh primerih se glivice v telesu zelo pogosto prekomerno razrastejo.
Prehrana z veliko sladkorja igra svojo vlogo. Neuravnotežena prehrana z veliko hitre hrane in nezdrava prehrana nasploh.
Hrana z veliko bele moke in k temu dodajmo še veliko stresa in slab spanec. In potem je tu še alkohol. To močno prispeva k večji nagnjenosti takšnih ljudi k črevesnim glivicam.


Imamo pa še eno težavo: hormone. Vemo, da estrogen spodbuja rast kvasovk. Zato so ženske veliko pogosteje prizadete, zlasti med nosečnostjo ali pri jemanju kontracepcijskih tablet. Spremeni se nam pH.
Torej, problem nastane, če je črevesna flora porušena, ko se dobre bakterije postopoma zmanjšujejo. Recimo, če pH vaše črevesne flore ni več primeren, ker je lahko postala preveč alkalna. To se lahko zgodi tudi, če zlorabljate sodo bikarbono v prahu. Bodite previdni, soda bikarbona ni čudežno zdravilo. Uporabljati jo morate selektivno, da se izognete škodi.
Če uporabite preveč sode bikarbone, če zvišate pH, pomeni, da ga naredite preveč alkalnega, potem to zagotovo spodbuja na primer širjenje kandide.
Pozor: posebej, ko gre za črevesne glivice, obstaja ogromno mitov in toliko napačnih informacij.
Od kod prihajajo glivice v črevesje
Prihajajo iz narave, iz okolja, iz hrane.
Na žalost je treba povedati, da so mnogi presnojedi, celo mnogi ljudje, ki kupujejo v ekoloških trgovinah, še posebej prizadeti zaradi tega. To vedno znova vidim v svojih raziskavah. Zakaj? Seveda, ker se fungicidi v ekoloških izdelkih ne uporabljajo.
Res je, ko se glivice zaužijejo s hrano, se takrat običajno eksplozivno razmnožujejo.
Kar pomislite na nepravilno posušene orehe ali odprto zrnje za mletje, zlasti iz ekoloških trgovin, ali celo koruza. Vse to je dovzetno za glivično kontaminacijo.
Sedaj pa ključna točka tega prispevka:
gliva ni dejanski problem.
Pravi problem je okolje,
ki ji omogoča, da postane tako močna.
Glavni krivec so zunanji dejavniki, zdravila, prehrana in stres.
To okolje se zaradi sodobnega načina življenja vse bolj slabša. Za mnoge ljudi je slabo, a se tega sploh ne zavedajo.
Pomemben okoljski dejavnik so težke kovine. Klasični primer so amalgamske zalivke v zobeh, kjer nenehno in latentno uživate živo srebro, sicer v zelo minimalnih količinah, vendar desetletja dolgo. Črevesna flora tega ne mara.
Za rast gliv morajo biti izpolnjeni določeni pogoji. Tudi jurčki in druge gobe v gozdu rastejo šele, ko so izpolnjeni pogoji za to.

Znanstveni spor
Tisti, ki ste bolj zdravstveno ozaveščeni, verjetno veste, da je prišlo do znanstvenega spora med Antoinom Béchampom in Louisom Pasteurjem.
Pasteur, ki ga poznamo iz pasterizacije mleka, je trdil, da vse bolezni povzročajo mikrobi, tj. bakterije, virusi itd.
Béchamp je temu nasprotoval in rekel, da je notranje okolje telesa ključnega pomena za to, ali zbolite, tj. ali se lahko borite proti bolezni ali ne.
Pasteur je nato na smrtni postelji domnevno rekel, da mikrob ni nič, okolje je vse. Tako je v zadnjem trenutku dal Béchampu prav.
Nato je približno 50 let pozneje v igro stopil še berlinski profesor Günther Enderlein, ki je prevzel nekakšno posredniško vlogo med obema in velja za utemeljitelja Sanum terapije in se z lastnimi raziskavami približal ugotovitvam Béchampa.
Naj povem, da se s temi dejstvi, vključno z glivicami in črevesnimi glivicami aktivno ukvarjam že od svojega 16. leta. In zdaj, več kot 30 let pozneje, mi je zadeva res jasna. Pogosto vidim bolnike s kroničnimi glivičnimi okužbami, ki so vzeli že na litre antimikotikov, glivice pa se vedno znova vračajo.
Skrbeti je treba za notranje okolje
Zato lahko eno stvar potrdim z absolutno gotovostjo: za to notranje okolje morate skrbeti, če se želite resnično znebiti teh gliv, saj sicer ne bo delovalo.
To je končno konec konvencionalnega medicinskega načina razmišljanja in tovrstne terapije črevesnih glivic. Ljudje so že prestali nešteto takih zdravljenj in bi lahko napisali cele knjige o tem.

Povrnimo se k Melaniejinemu primeru.
Dobila je precej redko črevesno glivo. To se je zgodilo njej, ki zelo skrbi za svoje zdravje in veliko naredi zase. V tem primeru je bila kriva fermentirana zelenjava in kislo zelje.
V njenem črevesju smo našli črno plesen Aspergillus. Pacientka je nato povedala, da je na svoji fermentirani hrani, ko jo je jemala iz kozarca, res opazila tanek film, a ni slutila, da bi lahko šlo za nevarno črno plesen.
V procesu zdravljenja smo prestrukturirali črevesje, pregledali nekaj toksinov in izvedli druge smiselne ukrepe. Končno je dobila nazaj svoje življenje, ne zato, ker smo ubili glivico, ampak zato, ker smo analizirali in strateško ponovno spremenili okolje. Čez dva ali tri mesece je Melanie spet sedela pred menoj brez napihnjenosti, brez možganske megle in brez hrepenenja po sladkem.
Pacientka se ni pozdravila zato, ker smo ubili glivico, ampak zato, ker smo analizirali in strateško ponovno spremenili okolje.
Zdaj se morda sprašujete, kako vem, ali morda v meni raste takšna glivica?
Oglejmo si tipične simptome
-
Pogosto napihnjenost in povečano nastajanje plinov.
To je zelo pogost simptom glivičnih okužb, zlasti kvasovk, kandide. Tudi te proizvajajo pline.
Zakaj?
Te kvasovke fermentirajo sladkor, ki nato proizvaja običajne osumljence: vodik, metan in CO2. To lahko seveda proizvajajo tudi gnilobne bakterije, na primer pri SIBO. Vendar pa to lahko počnejo tudi glive. To nato vodi h kopičenju plinov, občutku tiščanja, napihnjenosti in tako naprej. Še posebej pri obrokih, bogatih s sladkorjem ali sladko hrano, se prizadeti pritožujejo nad napihnjenostjo ter tiščanjem v želodcu. Seveda bi lahko šlo tudi za SIBO.
-
Pogosto spahovanje ali riganje
To lahko zamenjamo tudi s SIBO. Za tiste, ki ne vedo, kaj je SIBO, gre za prekomerno razmnoževanje bakterij v tankem črevesu, ki lahko prav tako proizvajajo pline (SIBO – ang. Small Intestine Bacterial Over growth – razraščanje tistih bakterij v tankem črevesju, ki so sicer zunačilne za debelo črevo – op.prev.).
Spahovanje pa lahko povzroči tudi kandida, spet kvasovka, s procesi fermentacije. Zadeva je podobna varjenju piva ali česa podobnega. Predstavljajte si, da se naberejo mehurčki in to lahko nato povzroči spahovanje.
-
Volčja lakota po sladkarijah
Ta glivična okužba ljudi žene v odvisnost od sladkorja. Sploh si ne moreš pomagati; sladkor moraš jesti redno, ker je biokemija preprosto tako močna. Zakaj? Kvasovke, zlasti kandida, kot glavni vir energije uporabljajo glukozo in druge vrste sladkorja.
Če se v črevesju preveč razmnožijo, lahko lokalno porabijo več sladkorja. Raven sladkorja v krvi niha. In to je sprožilec hrepenenja po sladkem.
-
Slabost
Slabost prav tako spada med možne simptome, ki so tudi posledica draženja črevesne sluznice. Tu povzročajo težavo glive, ki proizvajajo presnovne produkte etanol in kasneje acetaldehid in podobne stvari. To lahko nato draži center za bruhanje, počutiš se slabo oziroma imaš stalni občutek slabosti, bolečine v trebuhu, krče v trebuhu in tako naprej.
-
Prebavne motnje
Te se lahko pojavijo ne le zaradi draženja sluznice, ampak tudi zaradi nastajanja plinov. Ne prebavljate več tako dobro, kot ste vajeni. Prebavni encimi delujejo slabše, črevesna flora deluje slabše.
Posledica tega je neredno odvajanje blata, kot so driska, zaprtje, kašasto blato itd. To je precej pogosto, ko je sluznica že razdražena. Svojim pacientom to vedno razložim takole: sluznica gori.
Pacienti poročajo o možganski megli, težavah s koncentracijo, težavah s spominom, o občutku šibkosti ali praznine v glavi in o splošnem slabem počutju.
-
Občutek utrujenosti, splošna izčrpanost, popolna šibkost
Celo nenehna izčrpanost kljub zadostnemu spanju: to lahko dobro in vedno znova izmerimo pri testih blata. Kaj je vzrok? Presnovni toksini, kot je acetaldehid, ki obremenjujejo jetra.
-
Odpor do določene hrane
Opazujete lahko tudi paciente, ki postanejo manj lačni, ki razvijejo odpor do določene hrane, ker je sluznica tam preprosto razdražena. Torej, če nimajo več apetita, potem bi lahko imela težavo tudi črevesna flora.


Kandida
Kandida običajno ne živi le v črevesju, ampak tudi na drugih sluznicah, kot so ustna sluznica, koža vključno z vaginalno sluznico.
Tukaj je seveda težava, da vaginalne okužbe pogosto niso povezane le z okužbo vaginalne sluznice, ampak dejanska težava leži tudi v veliko večji črevesni sluznici. Enako je na primer pri tipični okužbi ušesa, ko imate te glivice v bistvu v ustih. To lahko sproži srbenje in pekoč občutek, zlasti v predelu ust, še posebej v nožnici in tako naprej. To se pogosto dogaja pri ženskah s cistitisom, ki morajo nato večkrat jemati antibiotike, kar pa je spet velik problem.
Ko smo že ravno pri teh težavah, ne dovolite, da bi vas kdo zavajal. Kandida ni samodejno vzrok teh simptomov. Obstaja veliko različnih simptomov: intoleranca na hrano, prekomerna rast bakterij, SIBO, gastritis, stres in tako naprej.
Obstaja veliko prekrivajočih se simptomov, ampak kot sem rekel, volčja lakota in tudi nastajanje plinov spadata med glavne simptome.
Kako lahko odkrijejo glive?
Seveda obstaja mikroskopsko odkrivanje glivičnih kultur. Pošljete blato, ga razmažete na agar-agar plošče in nato opazujete, ali gliva raste. Nato imamo kulturo oziroma določitev odpornosti natančne vrste gliv. Standardni test ni drag, torej lahko storite tudi to.
Obstajajo tudi testi protiteles, protitelesa IgM, IgG in IgA, proti glivam. Torej, to bi bil odvzem krvi, ki bi ga tukaj opravili, če bi bila v telesu okužba, na primer. Posredno lahko zaznate določene organske kisline. To so presnovni toksini, ki jih proizvajajo glive.
Pogosto imamo paciente, pri katerih so glive pod mejo zaznavnosti, vendar so morda še vedno tam, ker imamo problem, da se je na poti v laboratorij morda kaj zgodilo in tako naprej.
Torej lahko posredno ponovno ugotovite, ali obstaja sum na glivično okužbo. Sama prisotnost kandide v blatu nikakor ni dokaz okužbe. Kot sem rekel, v majhnem številu so del naravne flore.
Pomembno je vedno, koliko jih je, torej, kakšno je število bakterij in ali se ujema s klinično sliko. Če niste prepričani, ponovno opravite teste na te organske kisline. Zdaj vemo, kako pregledati te glivice.
Kot sem rekel, ugotovitev ali gre za glive je tako preprosta: le blato pošljete v laboratorij.
Kako se znebiti gliv
Veliko vprašanje pa je, kako se jih znebiti. Kot sem že omenil, nobenega smisla ni v jemanju protiglivičnega zdravila in upati, da bodo te izginile.
Tukaj potrebujemo trajno spremembo notranjega okolja. To pa vključuje spremembo prehrane. Prosim, izogibajte se preprosti, primitivni trditvi, da morate glivice stradati. Če spremenite prehrano le tako, da se odpovedujete sladkorju in beli moki, nato pa vzamete neke nadomestke tega, obstaja velika verjetnost, da ne bo delovalo. Govorim iz izkušenj.
Ja, prihajajo komentarji, češ, neumen zdravnik je proti vsemu in podobno. Ne, ne: tukaj imam izkušnje, saj se s tem ukvarjam že dolgo časa.
Človek ne more kar domnevati, da če je nekaj pri nekom delovalo, da bo delovalo tudi pri množicah. To je velik problem na internetu, z Instagramom in tako naprej. Nekdo se bo, na primer, znebil migrene. In postane vplivnež za migrene, ki pravi: “Sledite mojemu protokolu.”
In potem pričakujete, da se boste tako tudi vi znebili migren in črevesnih glivic in ostalih težav.
Ne, ne gre tako. Razmišljati in ukrepati moramo tako, da bo z zelo veliko verjetnostjo delovalo pri vseh. Seveda moramo okrepiti sluznice. Ponovno moramo vnesti dobre bakterije. Če so tam slabe bakterije, morajo oditi.
Kako ukrepati v primeru črevesnih glivic
Če ste eden tistih ljudi, ki imajo kar naprej črevesne glivice, vam lahko z absolutno gotovostjo zagotovim, da gre za dve najpogostejši regulatorni blokadi: težke kovine na eni strani in hormonski sistem na drugi.
Na vašem mestu bi najprej raziskal ti dve stvari.
Urediti je treba prehrano. Uživati je treba rastlinsko hrano in hrano z veliko vlakninami. To je bistveno za zdrav mikrobiom. Sekundarne rastlinske snovi ščitijo črevesno floro in sluznico. To je torej predpogoj.
Potem potrebujemo dobre probiotike, da lahko obnovimo floro.
Nisem proti konvencionalnim protiglivičnim zdravilom, toda jasno pravim, da se uporabljajo veliko prezgodaj.
Najprej je treba popraviti nekaj obstoječih stvari, še posebej, če zdravila že od začetka niso delovala. Misliti, da se lahko glivic znebite v 14 dneh z jemanjem nistatina, je primitivno poenostavljanje. To tukaj ni na mestu. Okolje je pravi problem. In če imate simptome, kot jih je imela Melanie, potem je treba takoj analizirati celoten mikrobiom.
Kratek povzetek ukrepov:
- Poskrbite za svojo črevesno floro (sprememba prehrane)
- Poskrbite za regulatorne blokade (razstrupljanje od težkih kovin; hormoni)
- Nato lahko uporabite tudi rastlinsko eterično olje in poskusite glivice obvladati z origanovim oljem ali čim podobnim.
- Šele, ko ste opravili vse te ukrepe, vzemite običajna protiglivična zdravila. Delujejo precej dobro. Vendar jih je treba uporabiti ob pravem času in nikakor ne prezgodaj.
Prevod in priredba video posnetka za branje: Mojca Zelenko
Vir: https://www.youtube.com/watch?v=cFWbkZtBtao
Različni laboratorijski testi dr. Selza : https://doktorselz.de/labordiagnostikdaheim/
Prispevki:
Mikrobiom je temelj imunskega sistema
Detox – kako razstrupiti in očistiti telo






Leave A Comment